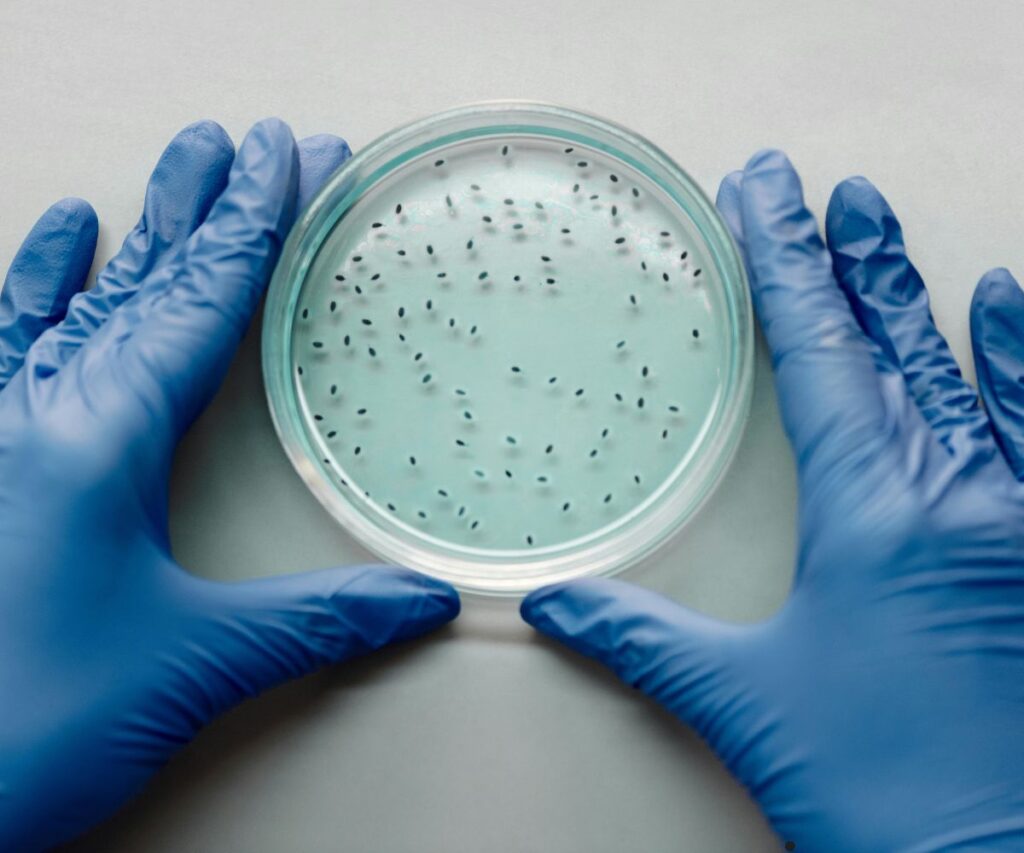
Job Update

भारतीय कृषि अनुसंधान परिषद – राष्ट्रीय पौधा आनुवंशिक संसाधन ब्यूरो (ICAR – National Bureau of Plant Genetic Resources, NBPGR) ने जूनियर रिसर्च फेलो (Junior Research Fellow – JRF) पद के लिए भर्ती अधिसूचना जारी की है। इच्छुक उम्मीदवार निर्धारित तिथि तक ऑफलाइन माध्यम से आवेदन कर सकते हैं। यह अवसर कृषि अनुसंधान के क्षेत्र में करियर बनाने की इच्छा रखने वाले उम्मीदवारों के लिए बेहद महत्वपूर्ण है।
पद का विवरण:
- पद का नाम: जूनियर रिसर्च फेलो (JRF)
- कुल पद: 01
- भर्ती का प्रकार: अस्थायी (Project Based)
- कार्य स्थान: ICAR-NBPGR, नई दिल्ली
शैक्षणिक योग्यता:
उम्मीदवार के पास किसी मान्यता प्राप्त विश्वविद्यालय से बायोटेक्नोलॉजी, प्लांट साइंस, मॉलेक्यूलर बायोलॉजी या संबंधित विषय में पोस्ट ग्रेजुएट (M.Sc.) डिग्री होनी चाहिए।
इसके साथ ही, उम्मीदवार के पास NET (CSIR/UGC/ICAR) परीक्षा उत्तीर्ण प्रमाणपत्र होना आवश्यक है।
वेतनमान (Salary):
- चयनित उम्मीदवार को ₹31,000 प्रति माह + HRA के रूप में वेतन प्रदान किया जाएगा।
आयु सीमा:
- अधिकतम आयु सीमा: 35 वर्ष
(OBC/SC/ST/महिला उम्मीदवारों के लिए नियम अनुसार आयु में छूट प्रदान की जाएगी।)
चयन प्रक्रिया (Selection Process):
उम्मीदवारों का चयन साक्षात्कार (Interview) के माध्यम से किया जाएगा। केवल शॉर्टलिस्ट किए गए उम्मीदवारों को साक्षात्कार के लिए बुलाया जाएगा।
आवेदन प्रक्रिया (How to Apply):
- इच्छुक उम्मीदवारों को आवेदन पत्र निर्धारित प्रारूप में भरकर सभी आवश्यक दस्तावेजों (शैक्षणिक प्रमाण पत्र, अनुभव प्रमाण पत्र, पासपोर्ट साइज फोटो आदि) के साथ दिए गए पते पर भेजना होगा।
- आवेदन केवल ऑफलाइन माध्यम से स्वीकार किए जाएंगे।
- लिफाफे पर स्पष्ट रूप से “Application for the post of Junior Research Fellow under DBT Project” लिखा होना चाहिए।
महत्वपूर्ण तिथि:
- आवेदन की अंतिम तिथि: 20 नवंबर 2025
पता (Address for Application):
The Principal Investigator,
DBT Project,
ICAR – National Bureau of Plant Genetic Resources (NBPGR),
Pusa Campus, New Delhi – 110012
महत्वपूर्ण निर्देश:
- उम्मीदवार को आवेदन भेजने से पहले अधिसूचना को ध्यानपूर्वक पढ़ना चाहिए।
- अधूरे या विलंब से प्राप्त आवेदन स्वीकार नहीं किए जाएंगे।
- चयन समिति का निर्णय अंतिम होगा।
निष्कर्ष:
ICAR-NBPGR में यह अवसर उन उम्मीदवारों के लिए विशेष रूप से उपयोगी है जो कृषि अनुसंधान, जैव प्रौद्योगिकी या पौधा विज्ञान के क्षेत्र में अनुसंधान अनुभव प्राप्त करना चाहते हैं। यह पद न केवल अनुभव प्रदान करेगा बल्कि भविष्य में अनुसंधान क्षेत्र में करियर को मजबूत करने का उत्कृष्ट माध्यम है।
Important Links
| Notifications | Click Here |
| Official Website | Click Here |